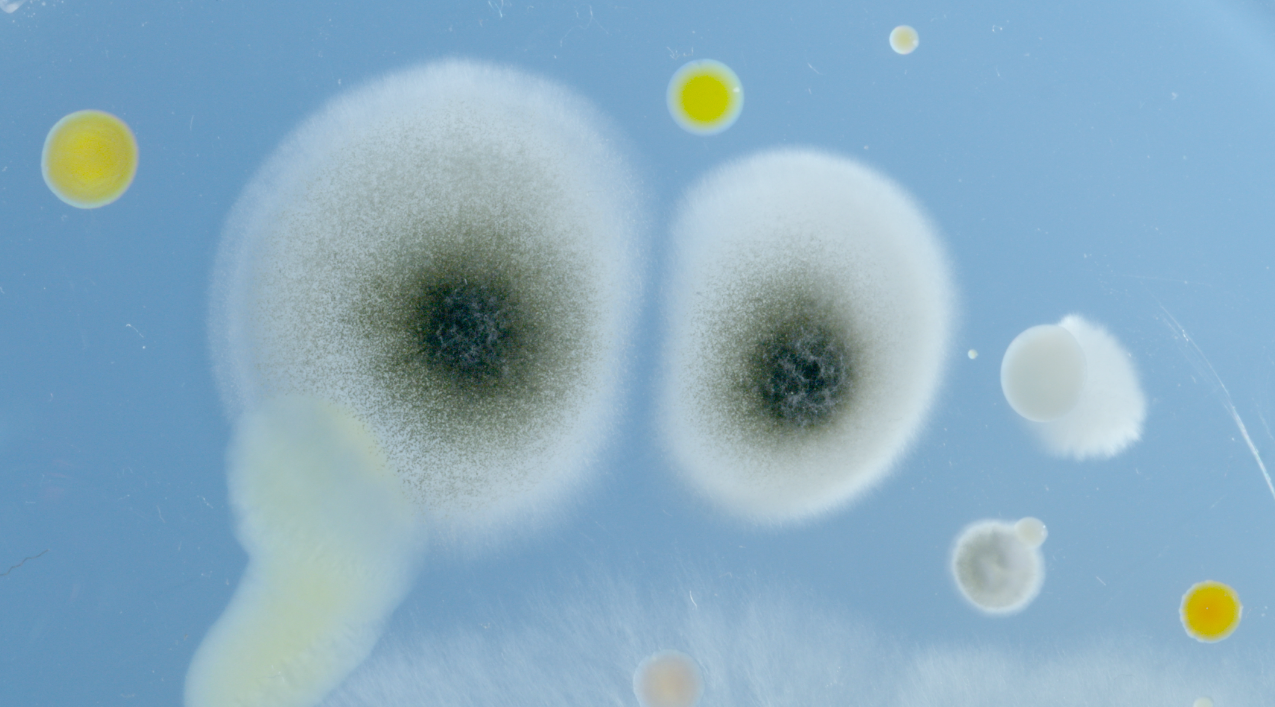

การสำรวจทางวิทยาศาสตร์นี้จะพาเราไปสู่ใจกลางโลกที่ยังไม่ค่อยมีใครเข้าใจ พร้อมเผยให้เห็นถึงความหลากหลายและความเปราะบางของอากาศที่เราหายใจเข้าไป
การสำรวจทางวิทยาศาสตร์นี้จะพาเราไปสู่ใจกลางโลกที่ยังไม่ค่อยมีใครเข้าใจ พร้อมเผยให้เห็นถึงความหลากหลายและความเปราะบางของอากาศที่เราหายใจเข้าไป แน่นอนว่าตอนนี้อย่างที่รู้กันดีว่าอากาศที่พวกเราใช้ในการหายใจอยู่นั้นไม่ได้บริสุทธิ์แบบที่เคยเป็นเพราะมีทั้งเชื้อโรคที่ลอยอยู่ในอากาศจากที่โรคติดต่อใหญ่อย่าง “โควิด” ที่ทุกคนต้องเคยประสบเจอเพราะเชื้อเหล่านั้นลอยอยู่ตามอากาศและหากเราไม่มีการป้องกันตัวเองที่ดีพอจะทำให้ได้รับเชื้อเข้าสู่ร่างกายในที่สุด ไม่เพียงแค่เรื่องของโรคที่เราสามารถติดได้จากเชื้อโรคที่ลอยอยู่ในอากาศ และในส่วนของ PM2.5 ที่ก็ยังคงเป็นปัญหากวนใจหลายคนเพราะด้วยการเติมโตของเมือง ฝุ่นควันจากรถยนต์ แม้กระทั่งการเข้าเผาป่าก็เป็นจุดเริ่มต้นของการที่เกิดฝุ่นละอองขนาดเล็กเข้าไปทำลายร่ายกายของของเราวันนี้ไม่พลาดที่ขอนำเสนอเรื่องราวของความน่ากลัวของอากาศที่เป็นพิษใน Microorganisms: The Air We Breathe แต่ก่อนที่จะติดตามเรื่องราวทั้งหมดในสารคดีวันนี้นำเสนอวิธีการช่วยลดปัญหาฝุ่นควันที่จะทำให้พวกเราทุกคนมีความสุขในโลกจะมีวิธีง่ายๆ ดังนี้ 1. งดเผาขยะ การที่เราเผาขยะไม่ว่าจะเป็นขยะทั้งจากธรรมชาติหรือไม่ธรรมชาติ ควรงด เพราะทำให้เกิดควันและปล่อยก๊าซพิเศษในอากาศ สามารถเปลี่ยนหากตั้งใจอยากเผาขยะควรเปลี่ยนมาเป็นฝังกลบ หรือนำไปทำปุ๋ยแทน 2. ปลูกต้นไม้เพื่อสร้างอากาศบริสุทธิ์ ต้นไม้สามารถปล่อยก๊าซดีสู่ชั้นบรรยากาศและยังช่วยให้อากาศของเราบริสุทธิ์ หากคุณมีพื้นที่ว่างจะต้องไม่พลาดที่ปลูกต้นไม้ โดยอาจจะเลือกจากต้นไม้ที่ชอบหรือต้นไม้ที่สามารถให้ผลเพื่อทานได้ เรียกว่าได้ประโยชน์ทั้งช่วยโลกและได้ผลไม้ไว้ทาน
3. ลดการใช้รถยนต์ส่วนตัว ใครที่กำลังมองหาวิธีในการช่วยลด แถมยังช่วยเงินในกระเป๋าคงหนีไม่พ้นการนั่งรถสาธารณะเพราะสามารถไปด้วยกันได้หลายคน ช่วยลดควันพิษสู่อากาศ หรือจะเปลี่ยนมาใช้รถไฟฟ้าในแบบที่เทรนด์รถยนต์ตอนนี้ก็เป็นอีกหนึ่งตัวช่วยที่ดี 4. ตรวจสอบรถยนต์เป็นประจำ เพราะการตรวจเช็กรถตัวเองไม่ให้ปล่อยพิษสู่อากาศก็นับว่าเป็นสิ่งที่ดี แถมยังช่วยลดโลกอีกด้วย
5. หมั่นตรวจสอบของใช้ที่บ้านทั้งแอร์ พัดลม เครื่องฟอกอากาศ เพราะการที่เราใส่ใจเรื่องเล็กๆ น้อยๆ อย่างของใช้ในบ้านก็จะสามารถทั้งช่วยลดค่าไฟ รวมไปถึงช่วยโลกได้อีกด้วย ถึงตอนนี้เชื่อว่าหลายคนคงอยากติดตามเรื่องราวของเชื้อร้ายที่ลอยอยู่ในอากาศผ่านสารคดี Microorganisms: The Air We Breathe กันแล้ว สามารถรับชมได้เลยวันนี้เวลา 20.03 น. ทาง True Explore Sci (561) #TrueVisions #Documentary #Microorganisms #Air #Breathe #ไวรัส #ฝุ่น #ป่วย #แบคทีเรีย #สารคดีมีที่ทรู
rection: Claude-Julie Parisot Production: Les Films en Vrac for ARTE France
อัปเดตข่าวล่าสุดก่อนใคร :
Website : www.truevisions.co.th
Facebook : Truevisions
Twitter : @TrueVisions
Line : @Truevisions
Youtube official : Truevisionsofficial
Instagram : TrueVisions Now

5. หมั่นตรวจสอบของใช้ที่บ้านทั้งแอร์ พัดลม เครื่องฟอกอากาศ เพราะการที่เราใส่ใจเรื่องเล็กๆ น้อยๆ อย่างของใช้ในบ้านก็จะสามารถทั้งช่วยลดค่าไฟ รวมไปถึงช่วยโลกได้อีกด้วย
ถึงตอนนี้เชื่อว่าหลายคนคงอยากติดตามเรื่องราวของเชื้อร้ายที่ลอยอยู่ในอากาศผ่านสารคดี Microorganisms: The Air We Breathe กันแล้ว สามารถรับชมได้เลยวันนี้เวลา 20.03 น. ทาง True Explore Sci (561)